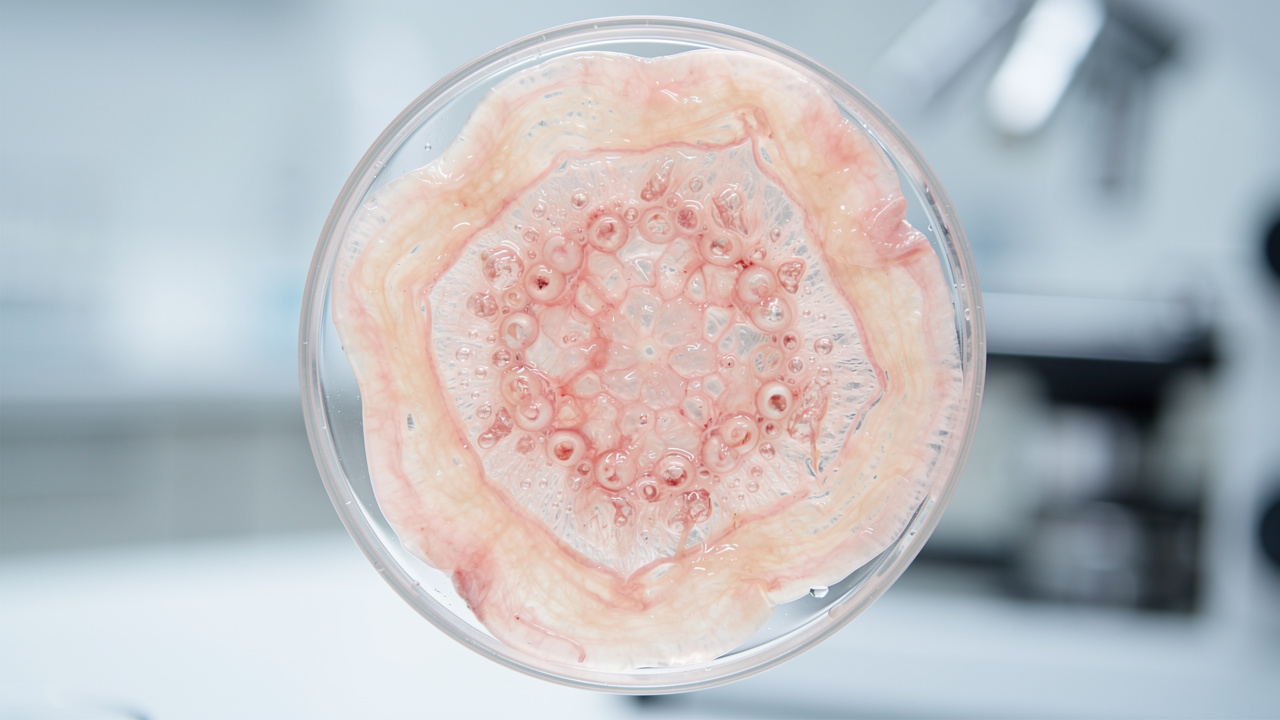
Ovarian tissue showing healthy follicles

Myo-Inositol vs D-Chiro-Inositol: What’s the Difference and Which Do You Need?
Standing in the supplement aisle and reading a label that just says inositol can feel a bit like reading the end of a story without the beginning. It gets even more confusing when one bottle mentions Myo-Inositol, another talks about D-Chiro-Inositol, and a third throws in a specific ratio. In that moment, Myo-Inositol vs D-Chiro-Inositol is not just a science question; it is a “what should I actually take” question.
Inositol is a vitamin-like compound the body uses for cell signaling, insulin function, and brain chemistry. It is sometimes called Vitamin B8, even though it is not a true vitamin. Within this family, Myo-Inositol (MI) and D-Chiro-Inositol (DCI) are the two forms that show up again and again in research on PCOS, fertility, metabolic health, mood, and even sleep quality.
Over the last decade, more people have turned to inositol to support PCOS symptoms, improve egg quality, smooth out blood sugar swings, and help calm the mind at night. That is good news, but it also means marketing messages can blur the real science. Many people do not realize that MI and DCI have different jobs in the body, and that the way they are combined matters as much as the total dose.
This guide walks through the full picture of Myo-Inositol vs D-Chiro-Inositol. You will see how they differ, why the well-known 40:1 ratio matters, where each shines on its own, and how they work together. You will also see how brands like SLP1 use inositol for nervous system balance and better sleep. By the end, you will be able to look at an inositol label and know what it is doing, whether it fits your goals, and how to discuss it with your healthcare provider.
Key Takeaways
-
Inositol is a family, not a single ingredient. It is a group of nine related molecules, and Myo-Inositol vs D-Chiro-Inositol is the key comparison because these two forms are the most active in human health. Myo-Inositol makes up about 99 percent of the body’s inositol pool, while D-Chiro-Inositol is made from Myo-Inositol in small, carefully controlled amounts.
-
Myo-Inositol and D-Chiro-Inositol work at different points in insulin signaling. Myo-Inositol mainly helps cells pull glucose out of the blood, supports ovarian function, and takes part in serotonin and dopamine signaling in the brain. D-Chiro-Inositol steps in later in the insulin pathway, helping store extra glucose as glycogen and influencing how the body handles androgens. When people compare Myo-Inositol vs D-Chiro-Inositol, they are really comparing “use sugar now” with “store sugar and shape hormones.”
-
The natural 40:1 Myo-Inositol to D-Chiro-Inositol ratio matters, especially for PCOS and fertility. Research points to a plasma ratio of about 40 parts Myo-Inositol to 1 part D-Chiro-Inositol. Staying close to this ratio in supplements is especially important for PCOS and fertility, because too much DCI can lower egg quality even though it can reduce excess androgens. Most people who want broad metabolic, hormonal, or sleep benefits do best with Myo-Inositol as the base, plus a smaller amount of D-Chiro-Inositol when needed.
Many integrative clinicians like to remind patients that “supporting hormones often starts with supporting insulin.” Inositol sits right in that intersection.
What Is Inositol? Understanding the Basics

Before comparing Myo-Inositol vs D-Chiro-Inositol, it helps to zoom out and look at inositol as a family. Chemically, inositol refers to nine stereoisomers. These molecules all share the same formula, but the atoms sit in slightly different positions in three-dimensional space. That small shift changes how each form fits into receptors and enzymes, and that changes what it does in the body.
Inositols show up in several important places:
-
They are part of the phospholipids that make up cell membranes, helping cells keep their shape and send signals.
-
They are found in lipoproteins in blood plasma, which carry fats through the bloodstream.
-
They appear as inositol phosphates inside the cell nucleus, where they help manage communication inside the cell.
In daily conversation and on most supplement labels, the word inositol almost always means Myo-Inositol. That is because Myo-Inositol accounts for about 99 percent of all free inositol in the body and is very easily absorbed. It has been known since the 1800s as a sweet-tasting, white, crystalline compound and is often grouped with sugar alcohols, even though it has a signaling role rather than acting like regular sugar.
Inositol is sometimes called a pseudovitamin or Vitamin B8, because the body can make it but also uses it in ways that look vitamin-like. It helps with three big tasks:
-
Supporting the structure of cell membranes.
-
Acting as a second messenger in insulin signaling, passing the insulin message inside the cell.
-
Helping regulate neurotransmitters such as serotonin and dopamine, which affect mood and sleep.
All nine forms of inositol exist in the body, but from a practical point of view, health research and supplements focus on just two. When people talk about Myo-Inositol vs D-Chiro-Inositol, they are looking at the main working form and the smaller, more specialized partner that the body makes from it.
Myo-Inositol (MI): The Body's Dominant Form

Myo-Inositol is the star of the inositol family. It is by far the most common form in human tissue, making up about 99 percent of free inositols. Because of that, when you swallow an inositol supplement, it is almost always Myo-Inositol unless the label clearly says otherwise. The body absorbs it well and moves it quickly into circulation.
In pure form, Myo-Inositol looks like a white, crystalline powder with a mild, sweet taste. Many powdered products mix easily into water and are pleasant to drink. But the real value of MI is not the flavor; it is the way this molecule sits in cell membranes and signaling pathways all over the body.
MI has three main jobs:
-
It is a building block for phosphatidylinositol, a key component of cell membranes that helps cells stay flexible and respond to signals.
-
It acts as a second messenger in the insulin pathway. When insulin docks on a cell, MI-based messengers help move glucose transporters, such as GLUT4, to the cell surface so glucose can move from the blood into the cell.
-
In the brain, Myo-Inositol is part of signaling for serotonin, dopamine, and other neurotransmitters that shape mood, focus, and the sense of calm.
When people ask why Myo-Inositol vs D-Chiro-Inositol shows up so often in PCOS and fertility research, MI is a big part of the answer. Decades of studies show that Myo-Inositol can improve insulin sensitivity, lower fasting insulin, and support regular ovulation in women with PCOS. In the ovary, MI is highly concentrated in the follicular fluid around developing eggs, where it helps with proper maturation and better egg quality.
Food does contain Myo-Inositol. It appears in fruits, beans, grains, and nuts. But hitting research-backed doses through diet alone is hard, especially for someone who also watches carbohydrate intake for insulin or blood sugar reasons. On top of that, some people with PCOS have issues with how their bodies handle MI, which makes dietary sources even less reliable for therapeutic use.
Most clinical studies on Myo-Inositol use daily doses between 2,000 and 4,000 milligrams. These doses are usually split into two servings for better tolerance and steadier levels. For many people, MI forms the base of their inositol plan, with D-Chiro-Inositol added in smaller amounts to fine-tune specific hormonal effects.
A common teaching in reproductive medicine is that “the ovary is a Myo-Inositol–rich environment.” That high MI presence is part of why egg quality is so sensitive to the MI–DCI balance.
D-Chiro-Inositol (DCI): The Specialized Metabolite
D-Chiro-Inositol is the quieter partner in the Myo-Inositol vs D-Chiro-Inositol story. You do not usually consume very much DCI directly from food. Instead, the body makes it on demand from Myo-Inositol by using an enzyme called epimerase. This enzyme shifts the position of one hydroxyl group on the ring, which turns MI into DCI.
This conversion is both insulin-dependent and tissue-specific. That means the body makes more DCI when insulin is present and in tissues where DCI is needed most. While MI is everywhere, DCI is far less common, making up about 1 percent of free inositols. The body tends to place it in tissues that store glycogen, such as the liver and adipose tissue.
DCI has a more specialized role than MI. After MI helps bring glucose into the cell, DCI helps decide what to do with the extra. One of its main tasks is to help signal for glycogen synthesis. DCI-based messengers activate glycogen synthase, the enzyme that strings glucose units together for storage. This helps the body save energy for later rather than leaving extra glucose to float around in the blood.
DCI is also involved in pathways that affect androgen production. Because of this, it has gained attention in PCOS, where high insulin and high androgens often go together. Some studies show that DCI can lower androgens like testosterone and DHEA-S, which may improve symptoms such as acne or excess facial hair.
However, the picture is not simple. In PCOS, there is what some researchers call a “DCI paradox.” Systemically, DCI levels can be low and linked with insulin resistance. Yet inside the ovary, the enzyme that converts MI to DCI can be overactive, leading to too much DCI in ovarian tissue. That oversupply appears to harm egg quality and ovulation. This is why DCI-only products, especially at higher doses, are not a good fit for women trying to conceive.
When you compare Myo-Inositol vs D-Chiro-Inositol, MI is the generalist that helps many tissues use glucose, while DCI is the specialist that guides storage and some hormone pathways. Because DCI is potent and the body normally keeps its levels low, therapeutic doses in supplements are small, often in the 50 to 100 milligram range per day.
The Critical Structural and Functional Differences
On paper, Myo-Inositol and D-Chiro-Inositol look almost the same. They are both six-carbon ring molecules with hydroxyl groups attached. The difference comes down to the orientation of just one of those groups in three-dimensional space. That slight shift changes how the molecule fits into various enzymes and receptor systems.
This is the heart of Myo-Inositol vs D-Chiro-Inositol:
-
MI-based compounds in the insulin pathway focus on getting glucose into the cell. When insulin binds its receptor, MI-derived second messengers tell glucose transporters to move to the surface of the cell so glucose can leave the bloodstream and enter the cell for immediate energy use.
-
DCI-based compounds step in after that first step. Their job is to support what happens once glucose is already inside. DCI-linked messengers stimulate glycogen synthase and other enzymes that convert extra glucose into glycogen, the storage form of glucose in the liver and muscles.
Both MI and DCI act as second messengers, which means they do not carry the insulin signal by themselves. Instead, they pass the message along inside the cell and turn on specific branches of the insulin response. Myo-Inositol mostly helps with glucose uptake and immediate use. D-Chiro-Inositol mostly helps with storage and with some hormone-related effects of insulin.
The body handles their placement with care. MI is widely spread through many tissues, including the brain and ovaries. DCI is more concentrated in glycogen-storing tissues such as liver and fat. In reproductive tissue, especially the ovary, the MI to DCI ratio is very high in favor of Myo-Inositol, which seems important for healthy follicle development and egg maturation.
Because of this, both sides of the Myo-Inositol vs D-Chiro-Inositol comparison matter. If you have plenty of MI but very little DCI, you may have trouble with glycogen storage and some hormone responses. If you push DCI too high in sensitive tissues such as the ovary, you may interfere with normal egg development. A healthy system keeps both available, but in very different amounts, depending on what each tissue needs.
The 40:1 Ratio: Why It's Physiologically Essential
The Science Behind the Ratio
When people talk about Myo-Inositol vs D-Chiro-Inositol, the 40:1 ratio comes up fast, with recent research providing an update on the physiological importance of this balance in plasma and tissue distribution. This shorthand refers to about forty parts Myo-Inositol to one part D-Chiro-Inositol in blood plasma. Research in healthy people shows that this is the rough balance the body tends to keep when insulin signaling and reproductive function are working well.
The body reaches this balance through controlled conversion of MI to DCI by the epimerase enzyme. Insulin helps regulate this conversion:
-
In tissues that need more glycogen storage (such as liver), more MI converts to DCI.
-
In tissues that rely more on rapid glucose use and signaling (such as ovaries), the body holds on to more MI and keeps DCI relatively low.
The plasma ratio is a snapshot of whole-body balance. Inside each tissue, the MI to DCI ratio can look very different. For example, the ovary has a far higher MI share than plasma, while liver has more DCI compared to many other organs. But across the system, that forty-to-one pattern in blood seems to match good metabolic and reproductive health.
Supplement studies support this idea. When women with PCOS use inositol in a 40:1 Myo-Inositol to D-Chiro-Inositol ratio, they often see better results in insulin markers, menstrual regularity, and ovulation than with either form alone. The logic is straightforward:
-
MI in that blend supports glucose uptake, ovarian signaling, and brain chemistry.
-
The smaller amount of DCI helps restore healthy insulin messages for storage without overwhelming sensitive tissues with too much DCI.
Why Deviating From 40:1 Can Be Harmful
It is tempting to think that if a little D-Chiro-Inositol helps with insulin and androgens, more must be better. This is where the Myo-Inositol vs D-Chiro-Inositol story can go wrong. Several studies show that high DCI doses or blends with much more DCI than the natural ratio can harm ovarian function.
In PCOS, this problem is even more clear. Many women with PCOS already have a kind of local DCI overload in their ovaries, even while other tissues may lack DCI. The enzyme that turns MI into DCI is overactive there. That leads to egg cells that see too much DCI and not enough MI, and research links this shift to poorer oocyte quality and trouble with normal follicle growth.
When you add large doses of DCI alone on top of that, ovarian DCI levels can climb higher. Animal and human studies suggest this may disrupt ovulation and lower the quality of eggs retrieved for IVF. So, while DCI can lower androgens and help insulin in some tissues, high levels in the ovary appear to work against fertility.
Ratios that stray far from forty-to-one, such as twenty-to-one or ten-to-one, move closer to this problem zone. They may still help some metabolic markers, but the safety margin for egg quality and ovulation gets thinner. That is why many experts advise women who are trying to conceive, or who plan to, to avoid DCI-only products and to pick blends that respect the physiological ratio.
Choosing a supplement that mirrors the body’s natural pattern supports both sides of Myo-Inositol vs D-Chiro-Inositol without tipping the scales in a way that can stress reproductive tissue.
Inositol's Role in PCOS: A Comprehensive Breakdown
How Insulin Resistance Drives PCOS Symptoms
PCOS is often labeled as a hormone problem, but insulin sits right in the middle of it. In insulin resistance, the body’s cells do not respond to normal insulin levels. To keep blood sugar in range, the pancreas sends out more insulin. This high-insulin state is called hyperinsulinemia.
That extra insulin does more than move glucose. It also acts on the ovaries, telling the cells there to make more androgens such as testosterone and androstenedione. As androgens rise, symptoms like acne, excess facial or body hair, and thinning scalp hair become more likely. Many of the visible signs of PCOS trace back to this pattern.
Insulin resistance also affects the hypothalamic–pituitary–ovarian axis, the brain-to-ovary communication loop. It can tilt the balance of luteinizing hormone (LH) and follicle-stimulating hormone (FSH), which are needed for normal follicle growth and ovulation. This shift raises the chance of anovulatory cycles, irregular periods, and difficulty conceiving.
Beyond reproduction, insulin resistance promotes weight gain around the waist and makes weight loss harder. It raises the long-term risk of type 2 diabetes, high blood pressure, and cardiovascular disease. So when you think about PCOS care, fixing insulin signaling is not a side issue; it is a central piece.
Many endocrinologists stress that PCOS management starts with insulin, stating that “if you calm insulin, other hormones often start to follow.”
This is where Myo-Inositol vs D-Chiro-Inositol matters. Both forms act inside the insulin pathway, but in different steps. Supporting those steps can ease the insulin load and soften many PCOS symptoms at their root.
How MI and DCI Address PCOS Differently
Myo-Inositol and D-Chiro-Inositol both help in PCOS, but they do not do the same job. Seeing the split makes it easier to pick the right approach for your own mix of symptoms.
Myo-Inositol in PCOS:
-
Improves how cells respond to insulin in muscle and fat tissue.
-
Helps glucose transporters move to the cell surface, so cells can bring in glucose and use it.
-
Reduces the need for high insulin output over time, which eases the signal that pushes ovaries to make extra androgens.
-
In the ovary, improves follicular fluid quality, supports proper egg maturation, and helps restore more regular ovulation and cycles.
D-Chiro-Inositol in PCOS:
-
Focuses more on what happens after glucose is already inside the cell.
-
Supports glycogen storage, helping remove extra glucose from circulation in a different way.
-
Often shows a stronger direct effect on androgens than MI, lowering testosterone, DHEA-S, and androstenedione more sharply in some studies.
-
May improve clinical signs of high androgens, such as acne and excess hair, in some women.
The most effective pattern for many women with PCOS is not a winner-take-all choice in Myo-Inositol vs D-Chiro-Inositol, but a blend in the natural forty-to-one ratio. In that mix:
-
MI takes the lead in fixing insulin resistance and nourishing ovarian function.
-
DCI adds extra support for androgen control and glycogen storage.
Together they can improve menstrual regularity, support ovulation, ease androgenic symptoms, and move metabolic markers such as fasting insulin and triglycerides in the right direction, without overloading the ovary with too much DCI.
Clinical Evidence: MI vs DCI Head-to-Head
Key Research Findings
To really understand Myo-Inositol vs D-Chiro-Inositol, it helps to look at studies that compare them directly. One of the most cited is a randomized controlled trial by Pizzo and colleagues, published in Gynecological Endocrinology. This study looked at women with PCOS and irregular cycles.
Fifty women joined the trial and were split into two groups for six months:
-
One group took 4 grams of Myo-Inositol plus 400 micrograms of folic acid each day.
-
The other group took 1 gram of D-Chiro-Inositol plus the same amount of folic acid.
Researchers tracked markers including body mass index, blood pressure, LH, FSH, total and free testosterone, DHEA-S, androstenedione, fasting glucose and insulin, and the HOMA index, which measures insulin resistance.
Both groups saw improvements, so both forms clearly helped. But the pattern of change was different, and that pattern lines up well with the different roles of MI and DCI in insulin signaling:
-
The Myo-Inositol group showed the strongest improvements in metabolic markers. Their glucose and insulin numbers shifted in a way that signaled better insulin sensitivity. The glucose-to-insulin ratio improved more, and the HOMA index dropped further.
-
The D-Chiro-Inositol group showed a stronger impact on androgens. Women in this group had a larger drop in total and free testosterone and often better changes in DHEA-S and androstenedione. Clinical signs of high androgens, such as acne and excess hair growth, tended to improve more quickly in many DCI users.
So the head-to-head data does not crown a single winner in Myo-Inositol vs D-Chiro-Inositol. Instead, it shows that MI is stronger on core metabolic problems, while DCI is stronger on direct androgen reduction.
What This Means for Treatment Selection
When you translate that study into daily life, the choice between Myo-Inositol vs D-Chiro-Inositol depends on your goals:
-
If insulin resistance, prediabetes, or weight gain around the middle is the main issue, Myo-Inositol alone can be a strong starting point.
-
If visible signs of high androgens, such as stubborn acne or coarse facial hair, are front and center, D-Chiro-Inositol has shown a stronger effect on those hormones.
-
If both metabolic health and fertility matter, research leans toward a 40:1 MI to DCI combination.
In practice, many clinicians use a forty-to-one blend as their first choice, then adjust with more MI or, in some non-fertility cases, slightly more DCI. No matter the mix, it is wise to work with a healthcare provider, use it consistently for at least three to six months, and track both lab markers and how the body feels.
Inositol and Fertility: Beyond PCOS
Mechanisms of Fertility Support
The Myo-Inositol vs D-Chiro-Inositol comparison matters even for people who do not have PCOS but do care about fertility. Inositol plays a role in egg and sperm quality, hormone balance, and even how the uterus receives an embryo.
For female fertility, Myo-Inositol is especially important:
-
Follicular fluid, the liquid that bathes developing eggs in the ovary, contains high levels of MI.
-
MI helps with folliculogenesis, the step-by-step growth of follicles that hold the eggs.
-
Adequate MI supports proper chromosome separation in the egg, which can lower the risk of abnormal embryos.
-
It helps fine-tune the balance of LH and FSH, which are needed for timely ovulation and healthy progesterone levels in the second half of the cycle.
-
MI appears to support the endometrium (uterine lining), helping create a better environment for implantation.
Research on male fertility is newer but encouraging. Early studies suggest that Myo-Inositol can improve sperm count, motility, and morphology. It may support mitochondrial function in sperm cells and protect them from oxidative stress, which can damage DNA and lower motility.
For both men and women, the ratio question still matters. Because DCI can lower egg quality when it is too high in the ovary, blends that match the physiological forty-to-one pattern are considered safer for fertility. In this context, Myo-Inositol vs D-Chiro-Inositol is not about picking the strongest single agent. It is about giving enough MI to support eggs and endometrium, while adding a modest amount of DCI to support insulin and weight without harming reproduction.
Supporting Assisted Reproductive Technologies (ART)
Inositol is also gaining a place in assisted reproductive techniques such as IVF and IUI. Many clinics now suggest Myo-Inositol before and during these treatments, especially for women with PCOS or insulin issues.
Studies show that women who take MI before an IVF cycle may:
-
Need lower doses of stimulation drugs to produce a good number of eggs.
-
Have ovaries that respond in a more predictable way.
-
Produce a higher proportion of mature eggs and better-quality embryos compared with those who do not use MI.
-
Have a reduced risk of ovarian hyperstimulation syndrome (OHSS) in some settings.
Typical protocols start Myo-Inositol, often in a forty-to-one blend with D-Chiro-Inositol, two to three months before an IVF or IUI cycle. This gives time for changes in egg quality, since egg development takes several months. Some clinicians continue inositol use through the stimulation phase and into early pregnancy to support blood sugar and reduce the risk of gestational diabetes, especially in women with PCOS or high BMI.
It is important to remember that inositol is an add-on. It supports the body alongside standard fertility treatment but does not replace procedures like egg retrieval, fertilization, or embryo transfer.
Fertility specialists often explain to patients that “supplements like inositol tune the system; they don’t replace medical procedures.” That framing keeps expectations realistic.
Metabolic Health Benefits Beyond Reproduction
Improving Insulin Sensitivity and Glucose Metabolism
Insulin resistance is not limited to PCOS. Many people with metabolic syndrome, prediabetes, or type 2 diabetes have the same basic problem: cells do not respond well to insulin, so blood sugar stays high and the pancreas has to work harder. Over time, this pattern wears on many organs.
Because MI and DCI are second messengers in the insulin pathway, they can support better glucose handling outside of a PCOS context too:
-
Myo-Inositol helps move glucose transporters to the cell surface, which makes it easier for muscle and fat cells to take up sugar after meals.
-
D-Chiro-Inositol helps move extra glucose into glycogen storage, keeping it out of long-term circulation.
With steady use, this two-step support can lead to smoother blood sugar curves, fewer sharp peaks after meals, and lower fasting insulin. People often notice fewer midafternoon “crashes” and more steady energy between meals. Weight management may become easier, because lower insulin levels send a gentler signal to store fat.
The balance between Myo-Inositol vs D-Chiro-Inositol remains important here. A forty-to-one blend gives strong support at both the uptake and storage steps without overshooting on DCI. This pattern appears in studies on gestational diabetes prevention, where women who take inositol before and during pregnancy develop fewer blood sugar issues, especially when they already have risk factors.
Lifestyle still sits at the base of metabolic health. No supplement can replace a nutrient-dense diet, regular movement, good sleep, and stress management. But for people already working on those pieces, inositol can be a helpful tool that works with the same insulin pathways that food and exercise affect.
Lipid Profile and Cardiovascular Markers
Insulin resistance and unhealthy lipid profiles tend to show up together. High insulin often goes hand in hand with high triglycerides, low HDL cholesterol, and sometimes higher LDL cholesterol. This mix raises cardiovascular risk over time.
By improving insulin sensitivity, inositol can soften this pattern. Studies with Myo-Inositol, especially in women with PCOS, show decreases in total cholesterol, LDL cholesterol, and triglycerides, with modest rises in HDL cholesterol. These changes mirror the shifts seen when people improve diet and activity and suggest that better insulin signaling helps the liver handle fats in a healthier way.
These benefits take time; lipid patterns change over months, not days. Inositol should sit alongside, not instead of, care such as dietary changes, exercise, and medication when needed. For someone already focusing on heart health, supporting insulin pathways with the right balance of Myo-Inositol vs D-Chiro-Inositol may give an extra nudge in the right direction.
Mental Health and Neurological Benefits

Mood Regulation and Anxiety Reduction
In the brain, inositol plays a signaling role just as it does in metabolic tissue. Myo-Inositol is a building block for inositol phosphates, which act as second messengers for several neurotransmitters, including serotonin and dopamine. These systems shape mood, anxiety levels, and how the brain responds to stress.
Clinical research has used high-dose Myo-Inositol, often between 12 and 18 grams per day, to study conditions like depression, panic disorder, and obsessive–compulsive disorder. Some of these trials have shown promising results, with MI performing comparably to certain medications in specific settings. Those doses are much higher than typical PCOS or metabolic doses, but they highlight how strongly MI can influence brain signaling.
At more common doses, such as 2 to 4 grams per day, many people report mood shifts that match what the science suggests. They describe feeling calmer and less on edge, with fewer racing thoughts and mood swings. Some notice that they do not react as sharply to stressors that used to trigger strong emotional spikes.
For people with PCOS, there is a double effect. Better insulin and hormone balance can smooth mood indirectly, while direct effects of MI on neurotransmitter signaling add another layer of support. The net result is often a steadier, less anxious emotional baseline.
When you compare Myo-Inositol vs D-Chiro-Inositol for mood, MI is the main player. DCI does not have the same depth of research in psychiatric use. Anyone considering higher doses for mental health should do so under guidance from a psychiatrist or other qualified clinician, especially if already taking medication. But even at lower doses, MI can be part of a thoughtful, science-based approach to mood support.
Cognitive Function and Energy Levels
The brain runs mostly on glucose. When blood sugar swings wildly up and down, many people feel it as “brain fog,” poor focus, and mental fatigue. Because inositol supports smoother insulin action and more stable glucose use, it can indirectly support clearer thinking.
People who start inositol for PCOS, metabolic health, or sleep often notice that their daytime focus improves. They describe less of a midafternoon crash, fewer moments of staring at the screen without being able to start a task, and easier recall of details. This fits with the idea that steady glucose supply helps neurons fire in a more regular and efficient way.
In addition, the calming effect that many people get from MI can remove a layer of mental noise. With fewer anxious or looping thoughts, it becomes easier to direct attention where it needs to go. Energy feels steady rather than jittery, which is very different from the buzz of heavy caffeine use.
Again, Myo-Inositol takes the lead here in Myo-Inositol vs D-Chiro-Inositol. DCI’s strengths lie more in metabolic storage and androgen handling. For someone who cares most about focus and mental clarity, MI-based formulas, sometimes combined with other gentle brain-supporting nutrients, are often the best fit.
Beyond PCOS: Other Therapeutic Applications
Support During Perimenopause and Menopause
Perimenopause, the years leading up to menopause, brings hormone swings that can affect mood, sleep, weight, and temperature control. Estrogen and progesterone rise and fall in less predictable ways, and many women notice that blood sugar control and weight maintenance become harder at the same time.
Even though research on inositol in this life stage is still limited, many long-term users report helpful effects. Women going through perimenopause while taking Myo-Inositol, often in a forty-to-one blend with DCI, describe:
-
Fewer and less intense hot flashes, especially at night.
-
Cycles that, while still changing, feel more orderly and less chaotic.
-
Less breast tenderness and fewer cramps.
-
A bit more mental clarity during a time when brain fog can be common.
Because inositol improves insulin sensitivity, it may also counter some of the metabolic shifts that happen as estrogen levels fall, such as increased abdominal fat and higher fasting glucose.
It is important to remember that inositol is not hormone replacement therapy. It does not replace estrogen or progesterone. Instead, it supports the metabolic foundation that often gets shaken during perimenopause and menopause. For a woman who already uses inositol for PCOS, mood, or sleep, staying on it during this transition may help soften some of the bumps along the way.
Potential Benefits for Metabolic Syndrome and Diabetes Risk
Metabolic syndrome is a cluster of issues that travel together: high blood pressure, high blood sugar, extra abdominal fat, high triglycerides, and low HDL cholesterol. At the center of this cluster sits insulin resistance. The more resistant cells become, the more the rest of the pattern tends to build.
Because both Myo-Inositol and D-Chiro-Inositol work inside insulin signaling pathways, they have drawn interest as tools for people with metabolic syndrome or prediabetes. Early research suggests that inositol, often in a forty-to-one blend, can improve fasting insulin, fasting glucose, and some lipid markers in these groups.
Studies in pregnant women at high risk for gestational diabetes show fewer cases of high blood sugar when inositol is used from early pregnancy onward. This is another sign that supporting insulin messages can reduce the chance of sliding into full diabetes, at least for some people.
That said, inositol is not a stand-alone treatment for metabolic syndrome or diabetes. It fits best as a partner to a lower-glycemic, whole-food diet, regular movement, and medications when needed. Anyone already on blood sugar medications should talk with a clinician before adding high-dose inositol, since better insulin sensitivity can sometimes lower glucose enough to require dose adjustments.
How SLP1 Uses Inositol for Sleep Optimization
For many health-conscious professionals and biohackers, interest in Myo-Inositol vs D-Chiro-Inositol started with PCOS or metabolic health and then moved into sleep. That is where SLP1 comes in. SLP1 was built around a simple idea: good sleep is less about forcing the brain to shut down and more about helping the nervous system follow its natural rhythm.
Inositol fits this view well. Myo-Inositol, in particular, takes part in serotonin and GABA signaling, two systems that help the brain shift from alertness into rest. When those systems work smoothly, the transition into sleep feels like easing down a gentle slope instead of falling off a cliff. Many people describe it as a calmer mind rather than a drugged feeling.
SLP1 uses inositol inside a three-part protocol that supports:
-
“Get to Sleep” – easing the transition from wakefulness to rest.
-
“Deeper Sleep” – supporting consolidated, restorative sleep cycles.
-
“Stay Asleep” – helping reduce nighttime awakenings.
Instead of relying on heavy sedatives or large doses of melatonin, SLP1 formulas use inositol alongside calming minerals and circadian rhythm–friendly ingredients. The goal is to steady the internal signals that tell the brain it is safe to relax, not to knock someone out.
Users often notice that inositol in this context has a steadying effect. There is less mental chatter at bedtime, fewer sharp emotional spikes at the end of the day, and a smoother slide into sleep. Because inositol is not a sedative, people tend to wake up feeling clear rather than groggy. Over time, this can build more consistent sleep patterns, which then support hormones, insulin, and mood in a positive loop.
SLP1 also pays close attention to details many supplement brands overlook:
-
Formulas are designed in-house rather than pulled from generic white-label blends.
-
Ingredients, including inositol, are used at clinically relevant doses and in forms that the body can absorb well.
-
The company uses third-party testing to check for potency and screen for contaminants, which matters to people who want clean, transparent products.
As SLP1 users often report, “the difference is not just falling asleep faster, but feeling calmer and clearer the next day.”
By working at the level of cell signaling, SLP1’s Bio-Sync approach lines up with the science behind Myo-Inositol vs D-Chiro-Inositol. Instead of overriding the body’s signals, SLP1 uses inositol and other nutrients to help those signals move more clearly. For someone who wants better sleep, sharper days, and more stable mood without feeling drugged, that style of support can be a strong match.
Practical Supplementation Guide
Determining the Right Form and Dosage for Your Needs
Turning research on Myo-Inositol vs D-Chiro-Inositol into a plan starts with your goals. Different mixes and doses fit different situations, even though there is plenty of overlap.
-
For broad PCOS management:
Many clinicians favor a 40:1 Myo-Inositol to D-Chiro-Inositol blend. A common daily dose is 4,000 milligrams of MI and 100 milligrams of DCI, usually split into two servings. This pattern supports insulin sensitivity, lowers androgens, and protects egg quality at the same time. -
For fertility support (with or without a PCOS diagnosis):
The same forty-to-one pattern is often used, at about 4,000 milligrams of MI and 100 milligrams of DCI per day. Most experts suggest starting two to three months before trying to conceive or starting IVF, since eggs take months to mature. With a doctor’s guidance, some women continue this plan into early pregnancy to support healthy blood sugar. -
For metabolic health and insulin resistance outside of a fertility focus:
Myo-Inositol alone or a forty-to-one blend can both work. Doses often range from 2,000 to 4,000 milligrams of MI daily, with 50 to 100 milligrams of DCI if using a blend. Some people with strong androgen symptoms may explore slightly higher DCI ratios under medical supervision, but the forty-to-one range remains the safest, most studied starting point. -
For mood and mental wellness:
Myo-Inositol is usually the main choice. Many begin with 2,000 to 4,000 milligrams per day and adjust based on response. Clinical trials in psychiatric conditions have gone much higher, but such doses should only be used with a clinician’s oversight, especially when medications are involved. -
For general wellness and preventive support:
A lower daily dose can make sense. One option is about 2,000 milligrams of MI with 50 milligrams of DCI, taken once per day. This gives gentle support for insulin and neurotransmitter signaling without pushing into full therapeutic dosing.
No matter which pattern you choose, consistency matters more than speed. Inositol works with cell signaling, and those shifts stack up over weeks and months. Splitting the total dose into morning and evening servings can keep levels steadier and often improves comfort for the digestive system.
Choosing a High-Quality Supplement

Not all inositol products are the same. When you understand Myo-Inositol vs D-Chiro-Inositol, it becomes easier to read labels and pick products that match the science rather than just the marketing.
Look for:
-
Clear MI/DCI ratio:
If you want a combination product, check that it stays close to the 40:1 Myo-Inositol to D-Chiro-Inositol pattern. Some blends use far more DCI than research supports, which may not be ideal for fertility or ovarian health. Clear labeling of both MI and DCI amounts per serving is a good sign. -
Adequate dose per serving:
A label might sound strong, but if one serving only gives 500 milligrams of Myo-Inositol, you would need many servings to match common research doses. Products that list 2,000 milligrams of MI and 50 milligrams of DCI per serving make it easier to reach clinical levels with one or two servings per day. -
Third-party testing:
Independent lab checks for purity, potency, and contaminants such as heavy metals or microbes show that a brand takes quality seriously. SLP1 is an example of a company that invests in this kind of testing, because their customers expect clean, reliable formulas. -
Appropriate form for your lifestyle:
Powders mix into water or other drinks and are often more practical at higher doses. Capsules are convenient and tasteless, which can help with long-term use. Some people open capsules and mix the powder into a drink, which gives more flexibility. -
Minimal unnecessary additives:
Good inositol products do not need artificial colors, synthetic flavors, or long lists of fillers. Simple formulas are easier to evaluate and are often kinder to sensitive stomachs.
A useful rule of thumb: if a supplement does not list exact amounts of Myo-Inositol and D-Chiro-Inositol, it is hard to know what you are really taking.
For those focused on sleep and nervous system balance, choosing a system like SLP1 that uses inositol inside a broader, rhythm-supporting design can make sense. For PCOS and fertility, many people prefer stand-alone inositol products they can pair with other guidance from their doctor. In both cases, understanding the balance between Myo-Inositol vs D-Chiro-Inositol helps you match the product to your aims instead of guessing.
FAQs
How Long Does It Take To Notice Results From Inositol?
Most people do not feel big changes overnight. For metabolic health, PCOS, and fertility, it often takes at least three months of steady use to see clear shifts in cycles, lab markers, or ovulation patterns. Mood and sleep changes may show up a bit sooner, sometimes within a few weeks. Because inositol works through signaling pathways, giving the body time to adjust usually leads to better and more stable results.
Can I Take Inositol With Other Supplements or Medications?
Inositol pairs well with many common nutrients, such as magnesium, omega-3 fats, and B vitamins. It is also included in multi-ingredient products like SLP1’s sleep system. If you take blood sugar medications, psychiatric drugs, or fertility hormones, it is important to talk with your healthcare provider before adding inositol. Better insulin sensitivity or mood signaling can change how you respond to your current plan, and your doses may need adjustment.
Is Inositol Safe To Use Long Term?
Studies and clinical use suggest that Myo-Inositol and D-Chiro-Inositol are generally very well tolerated, even at higher doses. The most common side effects are mild digestive issues, such as gas or loose stools, usually when starting or when doses are high. For most people, these fade as the body adjusts or when the dose is split. Long-term use has been common in PCOS and fertility settings without serious safety concerns reported, but regular check-ins with a clinician are still wise.
Do Men Benefit From Myo-Inositol Vs D-Chiro-Inositol Too?
Yes. Men can benefit from better insulin sensitivity, smoother blood sugar, and mood support from Myo-Inositol just as women do. Early research also suggests that MI can improve sperm quality in some cases. D-Chiro-Inositol may support metabolic health and androgen balance in men as well, although fertility-focused dosing is less clear. The same principles apply: higher MI, lower DCI, and close attention to individual response.
Should I Choose a General Inositol Product or a Sleep-Specific Formula Like SLP1?
The right choice depends on your main goal:
-
If PCOS, fertility, or metabolic syndrome is your primary focus, a straightforward 40:1 Myo-Inositol to D-Chiro-Inositol supplement makes sense, paired with guidance from your doctor.
-
If your top concern is sleep quality, nighttime calm, and next-day clarity, a system like SLP1 that uses inositol alongside other nervous system–supportive nutrients may be a better fit.
Some people use both, spaced out during the day, under professional guidance.
Conclusion
Inositol looks simple at first glance, but once you look closely at Myo-Inositol vs D-Chiro-Inositol, a clear picture starts to form. Myo-Inositol is the body’s main form, woven into cell membranes, insulin signaling, and brain chemistry. D-Chiro-Inositol is the focused partner that helps store glucose and shape androgen responses, present in much smaller, carefully controlled amounts.
Research shows that both matter, but not in equal measure. Myo-Inositol shines in improving insulin sensitivity, supporting ovarian function, and calming the nervous system. D-Chiro-Inositol is especially strong at lowering excess androgens. Together, in a 40:1 ratio that mirrors healthy plasma, they support PCOS care, fertility, metabolic health, and, when used thoughtfully, better sleep.
When you understand how each form works, inositol stops being a mystery powder and becomes a targeted tool you can use with your clinician.
Understanding this balance turns supplement labels from guesswork into informed choice. You can see whether a formula respects the body’s natural ratios, whether doses line up with research, and whether a product such as SLP1’s sleep system matches your actual goals. With that clarity, inositol stops being just another trend and becomes a precise tool you can use alongside lifestyle changes and professional care to support long-term health, performance, and rest.



Leave a comment
This site is protected by hCaptcha and the hCaptcha Privacy Policy and Terms of Service apply.